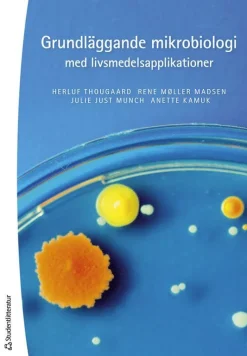
Grundläggande mikrobiologi med livsmedelsapplikationer -

Sale!
Ämnen A-Ö
Original price was: kr517.14.kr363.92Current price is: kr363.92.
Sale!
Ämnen A-Ö
Original price was: kr963.30.kr679.28Current price is: kr679.28.
kr588.02
Sale!
Ämnen A-Ö
Grundlig matematik : inledande matematik för ingenjörer, naturvetare och andra problemlösare
Original price was: kr537.42.kr395.36Current price is: kr395.36.
kr141.86
Sale!
Original price was: kr162.24.kr130.70Current price is: kr130.70.
kr1,003.76
kr232.10
kr303.08
kr252.38
kr434.90
kr273.68